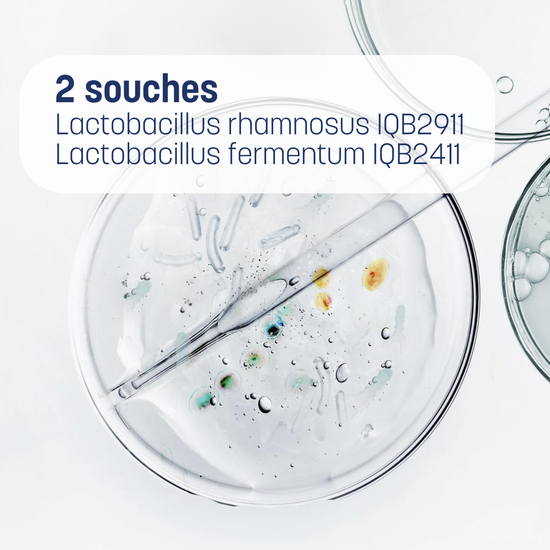

FEM NutriBiomix
Énergie féminine : tout commence dans l'intestin
Complément quotidien microbiote et nutriments
CE QU'IL Y A À L'INTÉRIEUR - et pourquoi ça marche
POURQUOI LE MICROBIOTE?
QUELS RÉSULTATS PUIS-JE ATTENDRE?
COMMENT PRENDRE FEM NUTRIBIOMIX









-

Formulé par des biologistes
-

Entreprise Belge
-

Livraison rapide et gratuite
-

Paiement sécurisé
POUR QUI?

Pour celles qui se reconnaissent dans ces ressentis :

Énergie en dents de scie, malgré une bonne hygiène de vie

Digestion inconfortable ou changeante

Sautes d'humeur, sensation de déséquilibre

Peau terne, manque d'éclat
Fem NutriBiomix est fait pour vous si vous voulez agir à la source : l'assimilation des nutriments par votre microbiote pour soutenir votre bien-être global (énergie, digestion, peau, équilibre...)

Fatigue persistante, digestion inconfortable, peau terne, cycles difficiles…
Ces signaux touchent de nombreuses femmes. Même avec un bon équilibre de vie.
Pourquoi ? Les causes sont multiples. Mais il y en a une qu'on néglige souvent : l'assimilation des nutriments. Ce n'est pas seulement ce que vous mangez, c'est ce que votre corps absorbe. L'assimilation des nutriments dépend de votre microbiote intestinal. S'il est déséquilibré, même les meilleures vitamines passent sans être pleinement utilisées.
Fem NutriBiomix soutient votre microbiote pour que votre corps profite enfin de ce que vous lui donnez : énergie, confort digestif, éclat.
Validé par la science du microbiote
Les chiffres qui parlent

“Seulement 2 semaines et je me sens déjà mieux, moins de ballonnements, plus légère, je reprends le contrôle!”
— Sanne U.
Données issues de la littérature scientifique. Les effets peuvent varier selon les profils.
Comment Fem NutriBiomix agit différemment
-
 Souches reconnues
Souches reconnuesSouches Microbiotiques ciblées
Fem NutriBiomix contient deux souches microbiotiques naturellement présentes dans l'intestin:
- Lactobacillus rhamnosus IQB2911
- Lactobacillus fermentum IQB2411
Leur rôle :
Participer à l'équilibre intestinal et créer un environnement favorable à l'absorption des vitamines et minéraux. -
 Assimiliation précise
Assimiliation préciseDosage en alternance
Votre corps n'a pas besoin de plus d'ingrédients. Il a besoin de mieux les absorber.
Fem NutriBiomix répartit ses nutriments sur deux gélules à prendre en alternance :- Jour 1 – Nutriments essentiels
Magnésium, Fer, Vitamines C, A, D3, B6, B9, B12, Biotine - Jour 2 – Microbiote + Oligo-éléments
Souches microbiotiques + Zinc, Sélénium, Calcium, Cuivre
Pourquoi ? Pour éviter la compétition entre nutriments et optimiser leur utilisation par votre organisme.
- Jour 1 – Nutriments essentiels

Par des biologistes, pour toutes les femmes
"L’efficacité des nutriments ne dépend pas seulement de ce que l’on prend, mais de ce que le corps peut réellement utiliser. C’est pourquoi nous avons placé le microbiote au cœur de Fem NutriBiomix."
SOPHIE HABRYN AND KRISTINA CUEVA
Biologistes et fondatrices de BIODAMI
Comment FEM NutriBiomix fait la différence

L'approche microbiote au service du bien-être féminin
La plupart des compléments se concentrent sur ce que vous prenez.
Nous, sur ce que votre corps absorbe.
Fem NutriBiomix agit là où tout commence : votre microbiote intestinal — la base de l'absorption des nutriments, de l'énergie, de l'immunité et de l'équilibre hormonal.
Prête à sentir la différence ?
Pourquoi 3 mois ?
Le microbiote a besoin de 6 à 8 semaines en moyenne pour se rééquilibrer durablement et optimiser l'absorption des nutriments.
1 mois

3 mois

5 mois

Questions fréquemment posées